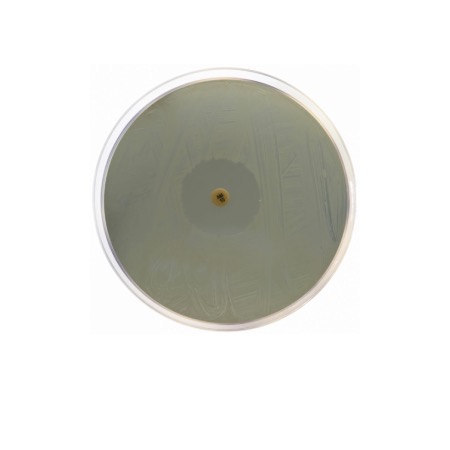
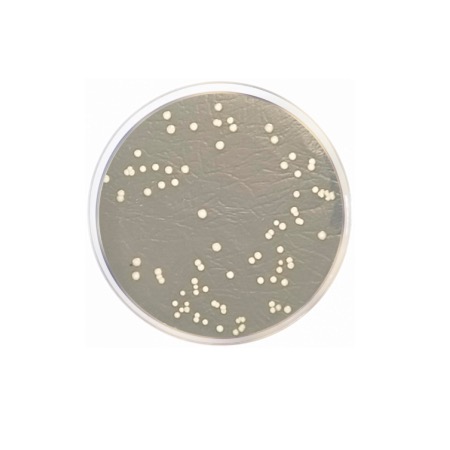
product

The formulation of Iso-Sensitest Agar is meticulously balanced to minimize the interference of antagonistic components that can affect antibiotic activity. It contains a specialized Peptone Mixture and Casein Hydrolysate to provide a stable source of nitrogen and amino acids. Glucose serves as the primary energy source, while a complex blend of Vitamins and Growth Factors (including Pyridoxine, Thiamine, and Riboflavin) ensures the growth of a wide range of bacteria. To ensure accurate results for sulfonamides and trimethoprim, the levels of Thymine and Thymidine are strictly controlled and kept at a minimum. The medium is also stabilized with a robust mineral and salt profile (including Magnesium Sulfate and Sodium Chloride) to maintain osmotic balance and provide the necessary ions for bacterial metabolism.
Advantages
- High Reproducibility: The semi-defined nature of the medium reduces batch-to-batch variation, leading to more consistent zones of inhibition.
- Antagonist-Free: Low levels of para-aminobenzoic acid (PABA) and thymine ensure the high sensitivity of sulfonamide and trimethoprim testing.
- Universal Growth: Supports the growth of the majority of common clinical pathogens, including Enterobacteriaceae, Staphylococci, and Enterococci.
- Optimized for AST: The mineral content is carefully adjusted to prevent the interference of divalent cations (Ca²⁺ and Mg²⁺) with aminoglycoside and tetracycline activity.
- Clarity: The medium is exceptionally clear, making the measurement of inhibition zones simple and accurate.
Technical specifications
| Catalogue number |
1001 |
| Brand |
Condalab |
| Application |
Antimicrobial Susceptibility Testing (AST) |
| Typical Composition (g/L) |
Special Peptone Mix (11.0); Casein Hydrolysate (11.0); Glucose (2.0); Sodium Chloride (3.0); Soluble Starch (1.0); Disodium Phosphate (2.0); Sodium Carbonate (0.6); Growth Factors/Minerals (0.8); Bacteriological Agar (8.0) |
| Final pH (at 25 °C) |
7.4 ± 0.2 |
| Preparation |
31.4 g/L |
| Storage Temperature |
2 – 25 °C |
Available packaging options
| 1001 |
500 g plastic bottle |

.jpg)